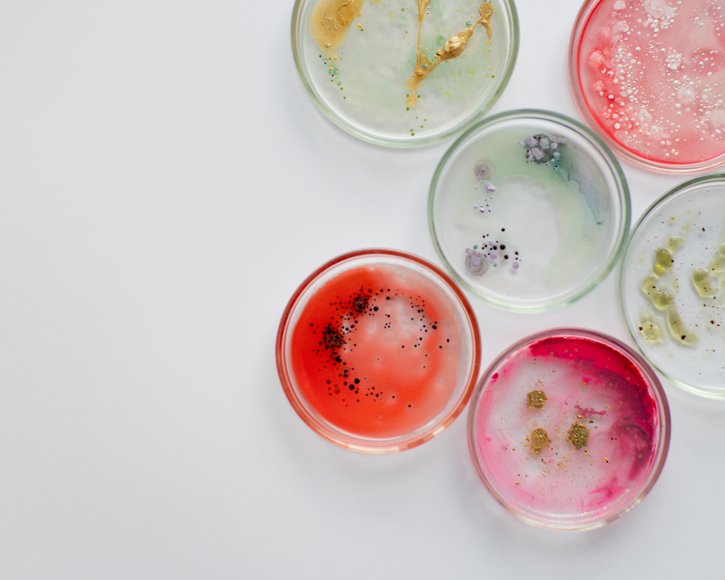
Den Blick schulen für Wunden und ihre Behandlung

Den Blick schulen für Wunden und ihre Behandlung
Heute ist der internationale 'Stop Wound Infection Day'. Das Thema hat große Beachtung verdient. Draco unterstützt Sie mit umfangreichem Informationsmaterial.
Wundinfektionen gefährden die Gesundheit. Das gilt sowohl für akute chirurgische Wunden als auch für heilende und nicht heilende chronische Wunden. Ein Problem stellen sie nicht nur für die Betroffenen da, denn die Weltgesundheitsorganisation (WHO) schätzt die zunehmenden Resistenzen gegen antimikrobielle Mittel als eine der größten internationalen Herausforderungen im Gesundheitswesen ein. Mit dem „Stop Wound Infection Day“ („Stoppen-Sie-Wundinfektionen-Tag“) soll das Thema stärker in das Bewusstsein der Beteiligten rücken. Das sind nicht nur Pflegefachpersonen, sondern auch Ärztinnen und Ärzte, MFA, Mitarbeitende in der Apotheke sowie Patientinnen und Patienten inklusive ihrer Angehörigen.
Das ist in diesem Jahr besonders wichtig, weil die anhaltenden Auswirkungen der COVID-19-Pandemie das Problem verschärft haben: Einige Patientinnen und Patienten sind mit Wundinfektionen zu spät zum Arzt oder zur Ärztin gegangen. Zudem haben in allen Professionen der Zeitdruck und die Arbeitsbelastung durch Corona zugenommen. Das kann dazu führen, dass Wundinfektionen später entdeckt werden.
Hintergrundwissen und Produkte
Umso wichtiger ist es, dass Fachpersonen regelmäßig ihr Wissen auffrischen. Wir haben dafür umfangreiche Informationen für Sie zusammengestellt. Hier lesen Sie, wie Sie infizierte (septische) Wunden am besten erkennen und behandeln. Außerdem können Sie in unserem Fach-Video alles Wissenswerte zum Thema „Antimikrobielle Wundversorgung“ erfahren.
Als praktische Hilfe bieten wir Ihnen die Produkt-Serie DracoFoam Infekt an – für eine bezahlbare dekontaminierende Wunderversorgung.
Quellen: